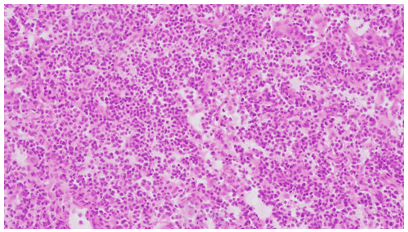
باثولوجي

El Sayed H.
نبذة عني
أنا مدخل بيانات دقيق ومنظم، أمتلك سرعة جيدة في الكتابة مع اهتمام كبير بالتفاصيل لضمان إدخال البيانات بشكل صحيح وخالٍ من الأخطاء. لدي القدرة على التعامل مع كميات كبيرة من البيانات وتنظيمها بكفاءة.
أجيد استخدام برامج مثل Microsoft Excel وGoogle Sheets في إدخال البيانات، ترتيبها، وتنظيفها، مع الالتزام التام بالمواعيد النهائية وسرية المعلومات.
أسعى دائمًا لتطوير مهاراتي وتقديم عمل عالي الجودة يلبي احتياجات العملاء بأفضل شكل ممكن.